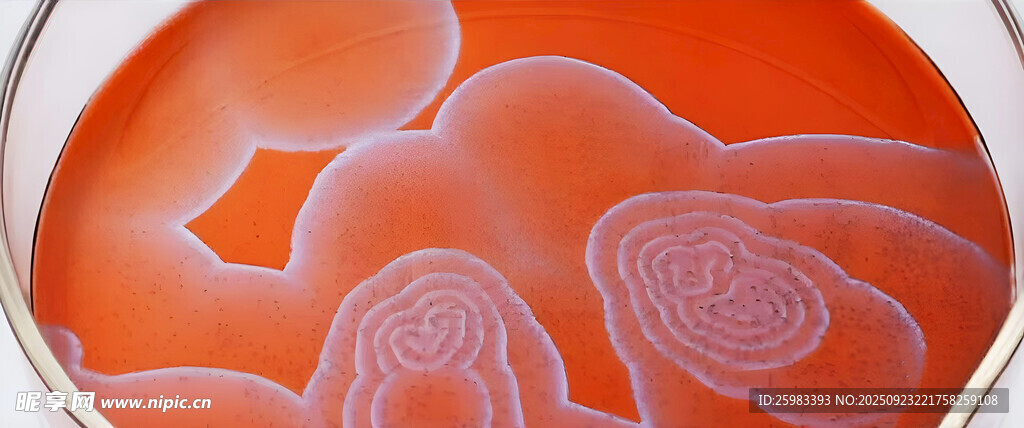

共享分: 100
编号:20250923221758259108
上传时间:2025/09/25
上传者:zhaoyimin2014
大小: 1.73 M
尺寸:3161×1320像素
格式:JPG
颜色:RGB
昵享网所有作品均是用户自行上传分享并拥有版权或使用权,仅供网友学习交流,未经上传用户书面授权,请勿作他用。若您的权利被侵害,请联系copyright@nipic.cn
|关 键 词:
Copyright © 2026 NiPic.cn All Rights Reserved 版权所有·昵享网 昵享网是网络服务平台方,若您的权利被侵害,请联系 copyright@nipic.cn
浙ICP备2022002922号-1 增值电信业务许可证:浙B2-20220223 违法和不良信息举报电话:0571-89267010